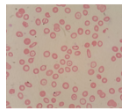
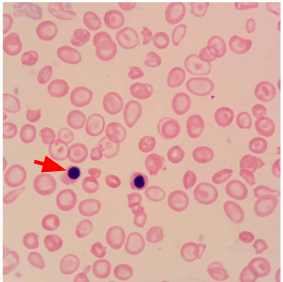
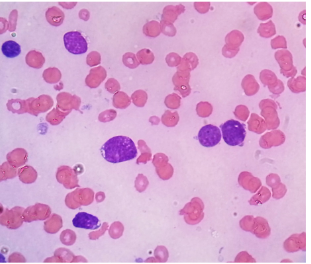
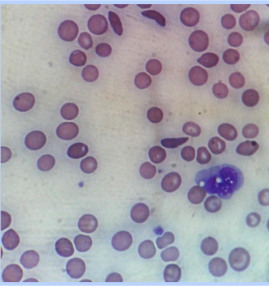
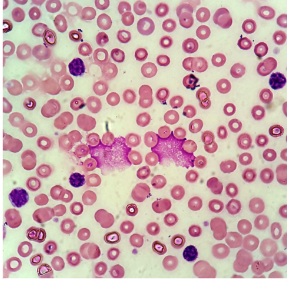
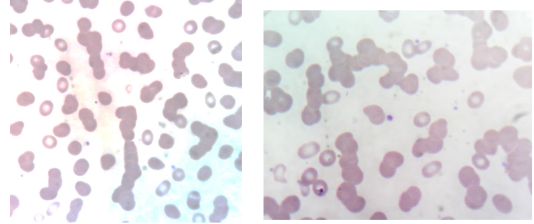
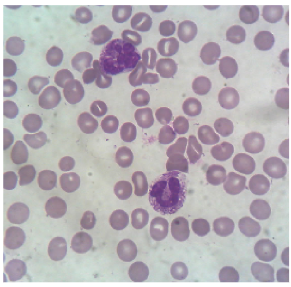
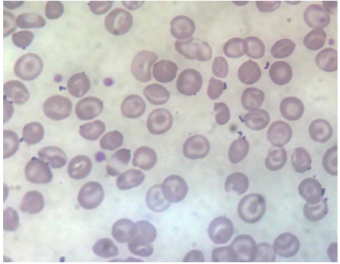

Haematology Objectives
Hematopoietic System: Its Source, Structure and Function
1. Identify the sites of hematopoietic tissue in fetal life, neonates and in adults.
2. List the cell lines in the bone marrow that are derived from the pluripotential stem cell.
3. Identify the growth factors (including cytokines), which influence the development of
the various cell lines.
4. Outline the role of connective tissue elements in hematopoietic function.
5. Introduction to hematological malignancies.
The Formed Elements of the Blood
6. Outline the development of red cells, granulocytes and platelets from the pluripotential
stem cell to the end cells.
7. Identify the sites of action of erythropoietin, GCSF and GMCSF.
8. Outline the factors, which lead to increased production of erythropoietin.
9. List the cellular components in peripheral blood.
10. Give the specimen tube/anticoagulant used to collect a specimen for a CBC/FBC. List
the different parameters in the CBC/FBC. Discuss the importance of the CBC/FBC.
11. List the functions of the erythrocyte and discuss its structure/ function relationship.
12. List the major blood group antigens. (e.g. ABO and Rhesus blood group systems in
humans. (Be aware that there are other Blood Group Systems both in humans and in
animals)
12
13. Explain the importance of blood group antigens in blood transfusion.
14. List the white blood cells present in peripheral blood. Give the functions of the different
white blood cells. Identify the different white blood cells on a blood film/smear.
15. List the features in the blood count and blood film that are associated with:
a. Bacterial infections
b. Viral infections
c. Chronic infections
d. Parasitic infestations
16. Describe the role of platelets in haemostasis.
17. Identify the difference between plasma and serum. List the components of plasma.
Describe the functions of the different plasma proteins.
18. Draw a diagram of intrinsic, extrinsic and final common pathways of coagulation and
complement systems.
19. Describe the vascular endothelium and its role in haemostasis as a pro-coagulant and
anti-coagulant surface.
20. Define bleeding time (BT), prothrombin time (PT) and partial thromboplastin time
(PTT) and state why these tests are important. Give the specimen tube/anticoagulant
used in collecting blood for performing the PT/APTT.
21. List the anticoagulants used in the laboratory and state their mechanisms of action.
22. Describe naturally occurring anticoagulants and outline their role in health and disease.
23. Describe the Fibrinolytic system
WHAT IS THIS IMAGE
IRON DEFICIENCY ANEMIA
small pink pencil shape cell
small pink pencil shape cell
Beta thalassaemia major
Beta thalassaemia major
Hyperchromic , nucleated red cells
WHAT IS THIS IMAGE
Acute lymphoblastic leukaemia
High N:C ratio
Scanty cytoplasm
Basophilic cytoplasm
Nuclear and cytoplasmic vacuolation
NAME THE IMAGE
Blood film in Sickle Cell Disease
Irreversibly sickled cells
Target cells
Irregularly contracted cells
NAME THE IMAGE

Chronic leg ulcers in SS Disease
IMAGE DISPLACING

Chronic Myeloid Leukaemia
NAME OF THE IMAGE
Chronic Lymphocytic Leukaemia
1. Small, mature lymphocytes
2. Clumped chromatin
3. * Smear cells
4.CD5, CD19
NAME OF IMAGE

Cold autoagglutination
IMAGE DISPLAYS

Cold autoagglutination
NAME OF THE IMAGE
Red cell rouleaux in myeloma
IMAGE DISPLAYS

Marrow plasmacytosis
59 yo diplomat
Back pain
IgA monoclone
Lytic bone lesions
NAME OF THE IMAGE
Neutrophils in septic patient
1. Toxic granulation
2. Cytoplasmic vacuolation
NAME OF THE IMAGE

Neutrophils in septic patient
1. Toxic granulation
2. Cytoplasmic vacuolation
IMAGE DISPLAYS
Haemoglobin CC Disease
IMAGE DISPLAYS

Hereditary Spherocytosis
NAME OF IMAGE

Immune thrombocytopenia
The diagnosis is:
Haemophilia A
Haemophilia B
Aplastic anaemia
This 24 year old wQ1oman has the following results: WBC 5.2 x 109/l, Hb 12.4 g/dl, Platelets 3 x 109/l.
NAME OF IMAGE

Warm Autoimmune Haemolytic Anaemia


